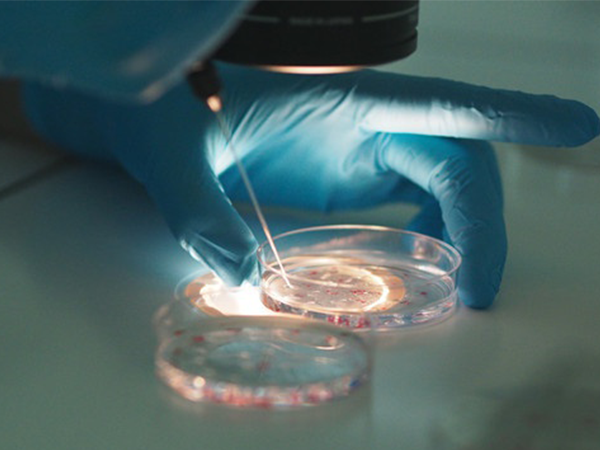

2022北京三代试管费用明细,总体不贵但也不便宜
- 试管婴儿经验
- 2023-07-15 09:05
北京经济发达,能做试管的医院也非常多,并且这些试管医院的医疗技术水平还比较高。北京的试管医院在医疗收费上其实和其他地区的医院没有太大差别,只是会因为医院等级不同收费会细微变化。在北京做三代试管婴儿总费用大概需要6~8万元左右,如果试管成功率比较高,试管收费相对来说也比较便宜,建议大家根据自身情况进项选择。
北京三代试管费用不贵但也不便宜
先怀孕,后付款-出生才是硬道理47岁1个卵泡一次成功经验分享不出国做三代-疫情下的试管新对策57岁供卵试管婴儿成功经验分享
助孕交流群
方法/步骤
北京是国内的经济、政治、文化中心,北京医疗资源丰富,能做试管的医院非常多,北京的医院开展试管婴儿技术的研究比较早,成功案例比较多,很多不孕不育家庭都想到北京做是试管助孕,但是北京的试管医疗费用是人们比较顾虑的。
促排卵费用高达10000元左右
北京一共有18家试管医院,这些医院中一共有3家医院能开展第三代试管婴儿技术,北京做三代试管的费用明细如下:
| 序号 | 步骤 | 具体详情 |
| 1 | 术前检查 | 术前的双方检查,检查项目比较多包括基础体检、男女双方的生殖检查以及染色体筛查等,大约需5000元左右。 |
| 2 | 促排卵费用 | 促排卵药分为进口药和国产药,进口药约250元左右一支,国产药物一支约需120元左右。每个女性平均需要20~30支,促排总的费用为3000~8000元,如果需要降调,额外还需要1000~2000元左右。 |
| 3 | 实验室操作费用 | 实验室操作费用包括(取卵、取精、胚胎培养、胚胎移植等费用)取卵取精+胚胎培养费用大概在600元左右,第三代试管移植前进行pgs或是pgd技术筛查,加上移植费大约3000元左右,这部分总的费用需要3~5万元。 |
| 4 | 验孕及保胎费用 | 验孕费用主要是B超费和抽血检查费,差不多在200~300元左右,验孕成功后黄体酮保胎费用为2000~300元左右。 |
Tips:
以上就是在北京做三代试管婴儿的总费用,北京经济消费水平比较高,相较于其他地区试管医疗费用差不多,但是生活花销更高,建议大家在赶赴北京做试管前,先准备好充足的预算。
北京做三代试管的经验分享
遥遥相望:备孕一年多一直没有怀孕,在本地医院做了人工授精失败,经朋友介绍到北京做第三代试管。因为我的身体情况符合做第三代试管,做一一到医院就开始进行检查,促排药用了25支,为提高成功率做的冻胚移植,移植第二次就怀上了,做试管一共花了8万多。
北京的试管技术比较先进
笑对生活:自然怀孕3次均流产,到医院检查医生建议做三代试管,因为还比较年轻,子宫内膜条件比较好,第一次移植就成功怀上。但是因为第一次促排效果不好,第二次改用进口促排药,所以一直到怀上一共花了快10万元。
坚强是我的伪装:我们家就住在北京,因为卵巢早衰,不得已做三代试管。卵子质量和子宫内环境都不好,刚开始以为会花很多钱的,没想到我还比较幸运,第一次囊胚移植就着床,仅仅只花了8万元就成功怀上了。

发表评论